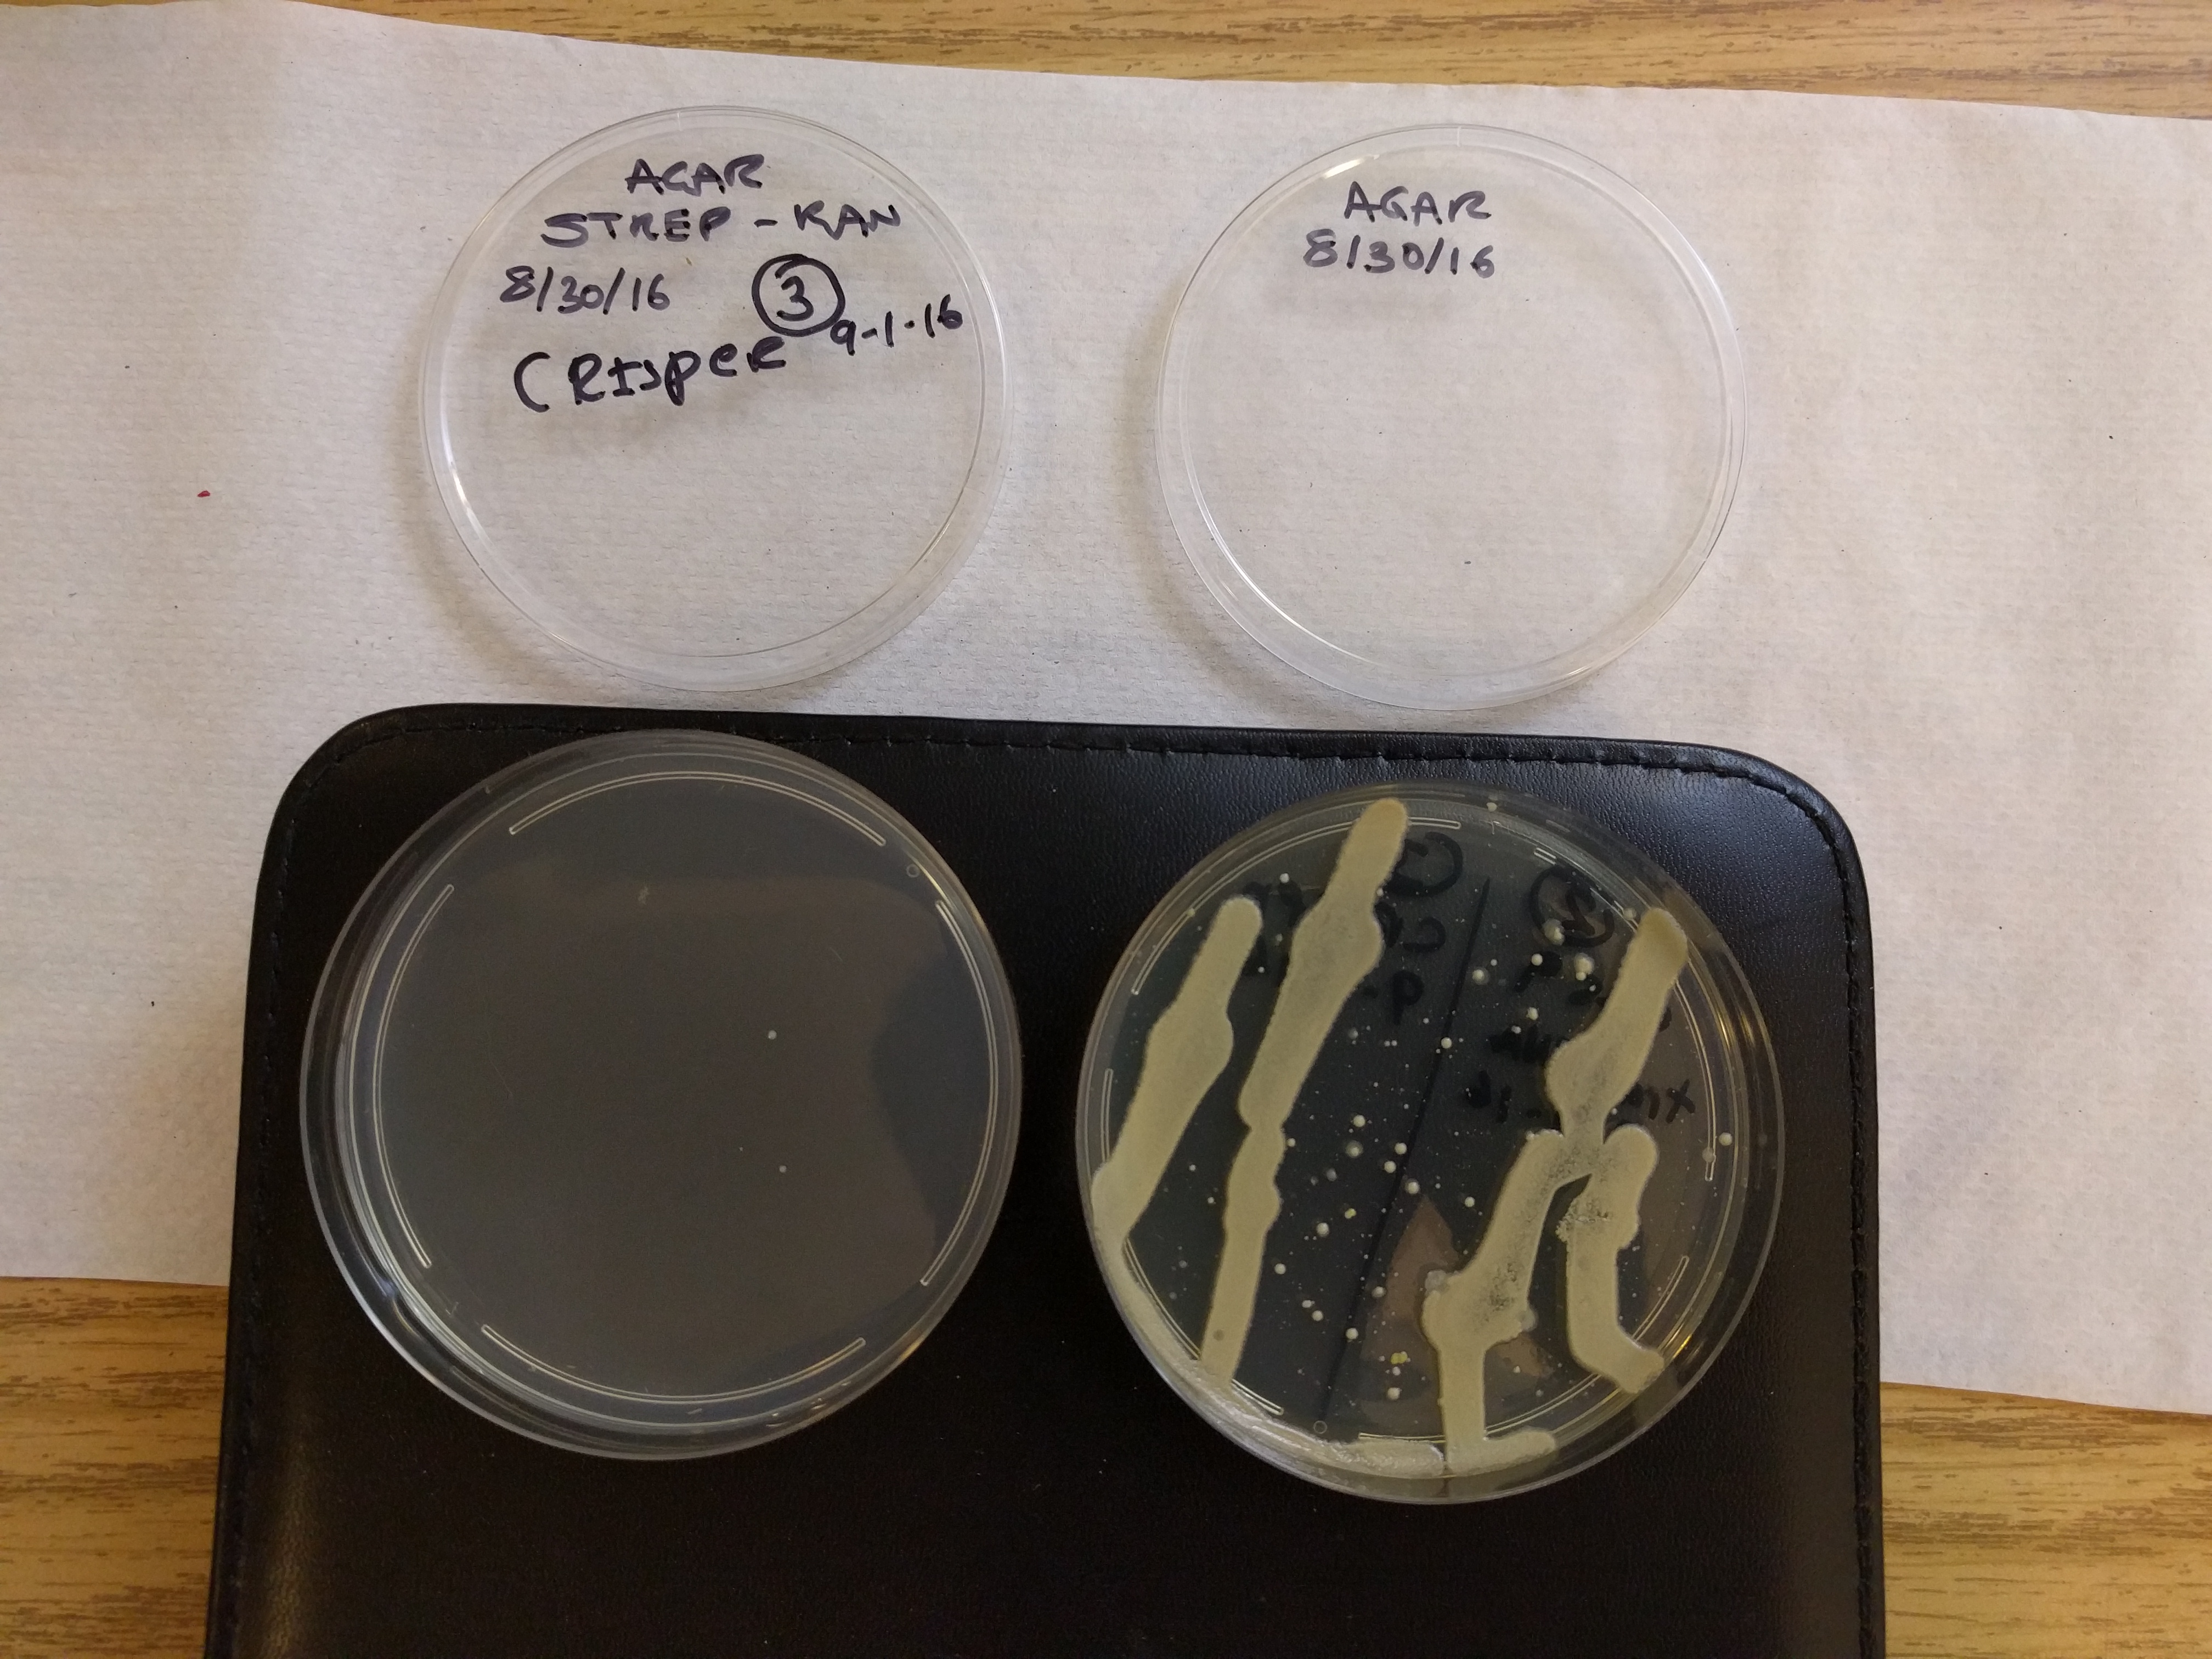

Uploads by Summakor
This special page shows all uploaded files.
| Date | Name | Thumbnail | Size | Description | Versions |
|---|---|---|---|---|---|
| 04:53, 19 June 2018 | Spaceblimp7 HackersSLS GSBC-Report.pdf (file) | 10.29 MB | Spaceblimp 7 (teams Hackers SLS) Global Space Balloon Challenge report. | 1 | |
| 22:50, 27 April 2018 | Sb7Accelg pop ftime.png (file) | ![]() |
48 KB | Spaceblimp 7 Accelerometer data (total XYZ) at Balloon Pop | 1 |
| 21:58, 27 April 2018 | Sb7Delay ftime.png (file) | ![]() |
130 KB | Spaceblimp 7 Accelerometer Measurement Delay Flight Time | 1 |
| 21:51, 27 April 2018 | Sb7Blue fltime.png (file) | ![]() |
43 KB | Spaceblimp 7 Sky Blueishness (B/RBG) Flight Time | 1 |
| 21:49, 27 April 2018 | Sb7Lux ftime.png (file) | ![]() |
37 KB | Spaceblimp 7 Illumination Flight Time | 1 |
| 21:47, 27 April 2018 | Sb7T ftime.png (file) | ![]() |
52 KB | Spaceblimp 7 Temperature Log Flight Time | 1 |
| 21:46, 27 April 2018 | Pglitch ftime.png (file) | ![]() |
35 KB | Spaceblimp 7 Pressure Log glitch | 1 |
| 21:45, 27 April 2018 | Sb7P ftime.png (file) | ![]() |
44 KB | Spaceblimp 7 Pressure Log vs Flight Time | 1 |
| 19:23, 27 April 2018 | SbPressure glitch.png (file) | ![]() |
41 KB | Spaceblimp 7 pressure log glitch | 1 |
| 19:04, 27 April 2018 | Sb7Pressure index.png (file) | ![]() |
42 KB | Spaceblimp 7 pressure log | 1 |
| 14:17, 10 April 2018 | CFC App Payment 2018.png (file) | ![]() |
58 KB | Statement showing payment of 2018 Combined Federal Campaign application fee by Enrique on 1/31/18 on card x8694. Receipt from CFC would be sent to treasurer@hacdc.org. | 1 |
| 02:01, 27 January 2018 | CRISPR-180112-StrepKan CrisprBact 48h.jpeg (file) | ![]() |
554 KB | Plate 8, Strep-Kan Agar, after being swirled with modified bacteria and growing for 48 hours. No growth is observed, unlike in plain Agar. The result suggests the bacteria survived the procedure but their genome was NOT modified to be resistant to stre... | 1 |
| 01:59, 27 January 2018 | CRISPR-180112-Agar Bact 48h.jpeg (file) | ![]() |
474 KB | Plate 1, plain Agar, after being swirled with modified bacteria and growing for 48 hours. The result shows a significant number of bacteria survived the transformation process and grow on plain Agar as expected. | 1 |
| 01:56, 27 January 2018 | CRISPR-180112-StrepKan blank 48h.jpeg (file) | ![]() |
509 KB | Plate 8, Strep-Kan Agar, after sitting at ambient temperature for 48 hours. No growth is observed, showing no contamination was introduced in the preparation. | 1 |
| 01:55, 27 January 2018 | CRISPR-180112-Agar blank 48h.jpeg (file) | ![]() |
37 KB | Plate 1, plain Agar, after sitting at ambient temperature for 48 hours. No growth is observed, showing no contamination was introduced in the preparation. | 1 |
| 14:14, 9 October 2017 | HacDC 2017-9 Projects.pdf (file) | 62 KB | Project Awesome project earmark balances September 2017 | 1 | |
| 14:12, 9 October 2017 | HacDC 2017-9 Report.pdf (file) | 92 KB | Financial report for September 2017. | 1 | |
| 00:39, 8 September 2017 | HacDC 2017-8.pdf (file) | 80 KB | Financial statement for August 2017 YTD. | 1 | |
| 01:22, 29 August 2017 | IMG 20170827 093620s.jpg (file) | ![]() |
14 KB | CRISPR Strep-Kan Plate 8/27 at 9AM | 1 |
| 01:18, 29 August 2017 | IMG 20170825 190912s.jpg (file) | ![]() |
37 KB | CRISPR Strep-Kan Plate 8/26 at 7PM | 1 |
| 01:08, 29 August 2017 | IMG 20170825 001628s.jpg (file) | ![]() |
26 KB | CRISPR LB-Agar Plate 8/25 12AM | 1 |
| 01:07, 29 August 2017 | IMG 20170825 001648s.jpg (file) | ![]() |
19 KB | CRISPR Strep-Kan Plate 8/25 12AM | 1 |
| 01:03, 29 August 2017 | IMG 20170825 190805s.jpg (file) | ![]() |
15 KB | CRISPR LB-Agar Plate 8/25 7PM | 1 |
| 01:02, 29 August 2017 | IMG 20170826 032748s.jpg (file) | ![]() |
20 KB | CRISPR Strep-Kan Plate 8/26 3AM | 1 |
| 01:01, 29 August 2017 | IMG 20170826 095042s.jpg (file) | ![]() |
15 KB | CRISPR Strep-Kan Plate 8/26 10AM | 1 |
| 23:56, 11 July 2017 | HacDC2017-6.pdf (file) | 78 KB | HacDC Treasurer's Report June 2017 | 1 | |
| 23:35, 13 June 2017 | HacDC-FiscalSponsorship.pdf (file) | 59 KB | Ken's proposal that HacDC act as a fiscal sponsor, a middle-man and financial oversight agent for non-profit grants executed by for-profit businesses (by subcontract to HacDC) | 1 | |
| 23:30, 13 June 2017 | HacDC HSTS MOUv3.pdf (file) | 68 KB | Version 3 of the HSTS-HacDC MOU | 1 | |
| 04:42, 13 June 2017 | HacDC 2017-5.pdf (file) | 77 KB | 1 | ||
| 04:24, 13 June 2017 | HacDC 2017-5 Projects.pdf (file) | 56 KB | HacDC Project Awesome project balances, allocations, expenses, earmarks | 1 | |
| 23:53, 8 June 2017 | HacDC2017-4.pdf (file) | 61 KB | Test treasurer's report April 2017 | 1 | |
| 03:20, 26 September 2016 | IMG 20160913 232219.jpg (file) | ![]() |
1.09 MB | Optical microscopy image 1000X of E.coli HME63 colony on Strep-Kan Agar | 1 |
| 03:13, 26 September 2016 | IMG 20160907 220305.jpg (file) | ![]() |
2.64 MB | 1 | |
| 03:10, 26 September 2016 | Jiang W Nat Biotechnol 2013.pdf (file) | 1.44 MB | 1 | ||
| 12:58, 25 September 2016 | HacDC NewsLetter 2016-9.pdf (file) | 954 KB | HacDC newsletter for September, 2016. | 1 | |
| 00:43, 14 September 2016 | HacDC 2016 - Report-9 (1).pdf (file) | 78 KB | Treasurer's report Sept 2016 | 1 | |
| 00:10, 10 August 2016 | HacDC 2016 - Report-8 (1).pdf (file) | 84 KB | Treasurer's report 2016-08-09 | 1 | |
| 05:11, 11 April 2016 | File-2016-April-Report.pdf (file) | 35 KB | 1 | ||
| 05:08, 11 April 2016 | 2016-April-Report.pdf (file) | 35 KB | Treasurer's report for April 2016. | 1 | |
| 03:57, 8 March 2016 | Meetup-2015-8.pdf (file) | 66 KB | receipt for MeetUp payment | 1 | |
| 04:56, 7 March 2016 | Treasurer Report 2016-3.pdf (file) | 58 KB | 1 | ||
| 04:13, 20 July 2015 | SEM data overlay OK.jpg (file) | ![]() |
153 KB | 1 | |
| 04:12, 20 July 2015 | SEM CCTV BNC Break.jpg (file) | ![]() |
52 KB | Located a break in the CCTV output. | 1 |
| 04:11, 20 July 2015 | SEM mainboard.jpg (file) | ![]() |
378 KB | The Cambridge StereoScan 200 SEM mainboard. | 1 |
| 04:11, 20 July 2015 | SEM soldering new pump relay.jpg (file) | ![]() |
168 KB | Soldering the new SEM pump replay in place. | 1 |
| 04:09, 20 July 2015 | SEM relay contact zoom.jpg (file) | ![]() |
89 KB | A microscope image of the original SEM vacuum relay contacts. | 1 |
| 04:08, 20 July 2015 | SEM vacuum relay broken.jpg (file) | ![]() |
88 KB | Close-up of the fragile original SEM pump relay. | 1 |
| 04:08, 20 July 2015 | Testing new SEM relay.jpg (file) | ![]() |
109 KB | Testing the new SEM pump relay. | 1 |
| 04:07, 20 July 2015 | SEM pump relays old.jpg (file) | ![]() |
222 KB | Original relays on the SEM pump control circuit. 120VAC relays with 24V DC trigger. The pumps pull about 15A. | 1 |